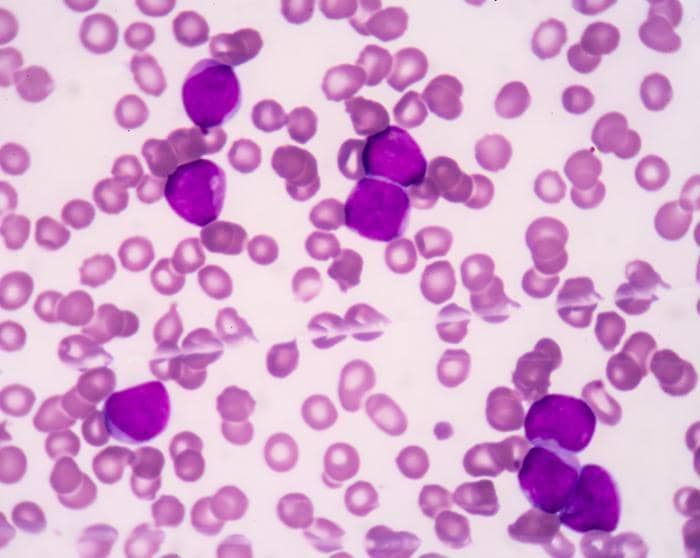
medicalnewstoday.com

Sering Mimisan? Jangan Sepelekan, Waspada 5 Penyakit Serius Ini

Mimisan merupakan pendarahan yang keluar dari hidung. Kalau sesekali mimisan, mungkin bisa saja karena kecapekan atau kepanasan dan itu masih wajar saja. Tapi, bagaimana jika mimisannya terjadi secara terus menerus ? Apa iya karena kecapekan atau kepanasan ?
Jangan dianggap sepele dulu nih, jika mimisan terjadi terus menerus. Mimisan yang terjadi terus menerus mungkin saja karena penyakit-penyakit serius.
Berdasarkan situs jurnal emedicine.medscape.com, berikut ini 5 penyakit diantaranya yang bisa menyebabkan mimisan
1. Juvenile Nasopharyngeal Angiofibroma

Berdasarkan jurnal medscape, Juvenile Nasopharyngeal Angiofibroma merupakan tumor ganas pada nasofaring, sering terjadi pada laki-laki remaja usia 7-19 tahun.
Gejala-gejalanya antara lain penyumbatan pada bagian hidung (80-90%) , mimisan yang terjadi pada salah satu lubang hidung dan terus menerus(45-60%) , sakit kepala (25%) , dan pembengkakan wajah (10-18%) .
Penderita Juvenile Nasopharyngeal Angiofibroma, terapi lini pertama biasanya dilakukan pembedahan dengan tujuan mengangkat sebanyak mungkin tumor. Idealnya seluruh tumor dapat terangkat. Namun beberapa situasi, tergantung penyebaran tumor, pengangkatan total tidak mungkin dilakukan.
2. Acute Myeloid Leukemia ( AML )
Sama seperti Juvenile Nasopharyngeal Angiofibroma, Acute Myeloid Leukemia atau AML juga merupakan penyakit keganasan, yakni salah satu jenis kanker sumsum tulang yang menyerang tempat pembuatan sel-sel darah baru.
Tanda-tanda umum seseorang mengidap AML antara lain berat badan menurun, lelah otot, demam, keringat berlebihan pada malam hari, dan nafsu makan menurun.
Menurut cancer.org, AML menyebabkan jumlah sel-sel darah ( sel darah merah, sel darah putih, dan keping darah) menurun. Jumlah keping darah yang menurun mengakibatkan beberapa gejala-gejala yaitu memar pada kulit, mimisan yang sering dan berlebih, dan perdarahan gusi.
Biasanya, penderita AML akan mendapatkan perawatan berupa kemoterapi.
3. Hemofilia B

Berbeda dengan dua diatas yang merupakan suatu tumor dan kanker, Hemofilia B merupakan kelainan genetik karena kekuranga faktor pembekuan darah.
Berdasarkan jurnal medscape, kasus hemofilia B terjadi sekitar 20% dari sejumlah kasus hemofilia. Selain itu, berdasarkan survei World Federation of Hemophilia (WFH) pada tahun 2010, terdapat 25.160 penderita hemofilia B.
Gejala utama hemofilia B adalah perdarahan. Perdarahan dapat terjadi di berbagai tempat bagian tubuh antara lain mukosa mulut, gusi, hidung, saluran kemih, sendi lutut, pergelangan kaki dan siku tangan, otot iliospoas, betis dan lengan bawah.
Untuk memastikannya apakah benar menderita Hemofilia B, dokter akan melakukan pemeriksaan fisik dan laboratorium guna menegakkan diagnosis.
4. Osle Weber Rendu Syndrome atau Hereditary Hemorrhagic Telangiectasia

Hereditary Hemorrhagic Telangiectasia ( HHT ) merupakan kelainan pada pembuluh darah yang menyebabkan seringnya perdarahan. Penyakit ini disebabkan oleh mutasi genetik sehingga dapat diturunkan.
Kriteria utama pada HHT adalah mimisan spontan dan berulang ( 90% ), Telangiektase kulit atau pelebaran pembuluh darah kecil ( 75% ), gangguan hati dan paru ( 30% ), dan perdarahan sistem pencernaan (15% ).
Berdasarkan medscape, pasien dengan penyakit HHT ditangani dengan terapi medis dan pembedahan yang ditujukan untuk mengurangi jumlah perdarahan dan meminimalkan sekuele kerusakan pembuluh darah yang dapat berkembang pada beberapa sistem organ.
5. Rhinoscleroma

Rhinoscleroma pertama kali ditemukan tahun 1877, menurut jurnal Medscape. Rhinoscleroma merupakan penyakit kronis granulomatosa yang berbentuk nodul kecil pada hidung dan sering menginfeksi sistem pernapasan atas. Penyakit ini disebabkan oleh bakteri Klebsiella rhinoscleromatis .
Gejala-gejala rhinoscleroma antara lain penyumbatan hidung, perubahan bentuk hidung, sulit bernapas, dan mimisan.
Penderita Rhinoscleroma akan dilakukan bronkoskopi yang memiliki peran dalam pengobatan gejala awal. Perawatannya juga mencakup terapi antimikroba jangka panjang yang disesuaikan dengan usia dan jenis kelamin serta pembedahan pada pasien dengan gejala penyumbatan hidung, menurut jurnal Medscape.
Itulah 5 penyakit serius yang salah satu gejalanya mimisan yang terjadi terus menerus. Kalau kamu merasa ada yang nggak beres dengan frekuensi mimisanmu, segera periksakan ke dokter saja.
Semoga kamu nggak mengalaminya, ya!


![[QUIZ] Siapakah kamu sebenarnya?](https://image.rujakcingur.com/post/20250611/1401x788-Screen-Shot-2015-01-18-at-8.29.01-AM_zpsaxbn64rp.png)

.png)













